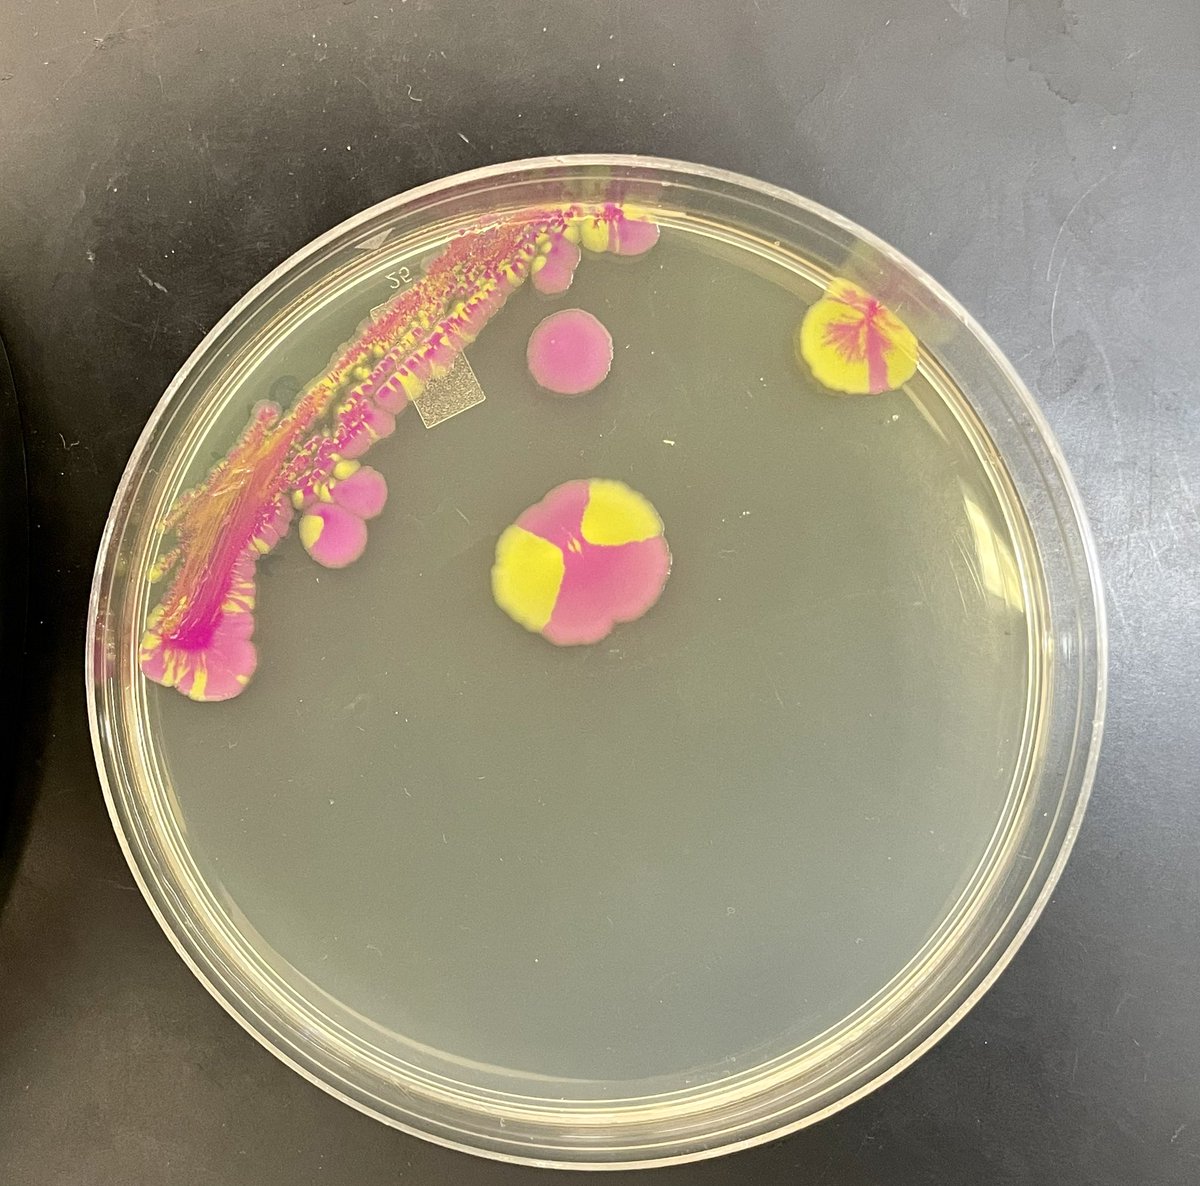
Mark O. Martin tweet media

Sabitlenmiş Tweet
Ryan A Valdez
686 posts


Ryan A Valdez
@BioSciRy
Queer latine scientist; something approximating a microbiologist; they/he, in all my non-binary finery 🏳️🌈🌵🌱🦠
Katılım Şubat 2019
830 Takip Edilen432 Takipçiler

@PracheeAC That emoji usually follows me saying "but that's none of my business", so I guess I use it to say I'm being nosy.
English

@gramnegativity I went back and forth trying to decide if it was worse to leave it out and look like I don't know it should be italic or add [i][/i] and maybe look like I can't use technology. 😭
English

@PracheeAC I used to think it would magically stop being hard at some point, but I've come to realize it's more of a "yeah, okay, I can roll with that" situation. Godspeed!
English

@charliejhadley This is super helpful. I've been debating whether it felt honest to include R on my CV because I really only use it for data visualization. To my embarrassment, I hadn't considered just specifying that. Lol 😅
English

@katiedimartin Obviously! It's right there in your bio. "Having a bad time and being a philosopher all the time, for sure, but don't check or ask any follow-up questions" sends a pretty clear message.
English

@itatiVCS Student uses mentor's support in a socially and professionally challenging situation - what an absolute monster (/s). I would have done the exact same thing.
English

@VectorSciNikki It's behind us in the sense that it's also in front of and around us. Lol
English

@katiedimartin Fat is such a wild insult like... yeah, you got me. That's a factual statement about the body I inhabit. Do you want a prize for noticing? Lol
English

I love my project. I love my lab. I am determined to succeed come Hell or high water. I am also determined to rest and spend time on the other things I love. I am determined to respect myself and the quality of my work by not pushing past my healthy limits.
alex a@alexabelson9
@seis_matters So many of the responses apparently can’t conceive of a person who is excited about doing research and determined to be successful, even in exchange for some amount of personal enjoyment or free time. It is pretty hard to have a productive PhD with a clock-in clock-out mentality.
English

@DrRachaelF A very helpful tool for such things: 10minutemail.net/m/?lang=en
English
Ryan A Valdez retweetledi

@katiedimartin I wanna place my bet that this man really wrote a 25 tweet thread to justify his "hot for teacher" fantasy.
English

@LizWFab However, I think there's a layer of disrespect for the learning community you're in (i.e. prof, other students, TAs) in opting not to engage.
English

@LizWFab To the professor? Yes, but largely because most students know a professor would interpret the action that way and elected to do it anyway. Like clapping my hands is not disrespectful, but clapping my hands when I've been (perhaps implicitly) asked not to is disrespectful.
English

If that city is St. Louis... well, good luck.
soul nate@MNateShyamalan
the saddest thing is when you visit a city that’s not new york or chicago and they’re like “we also have a distinctive pizza style!”
English